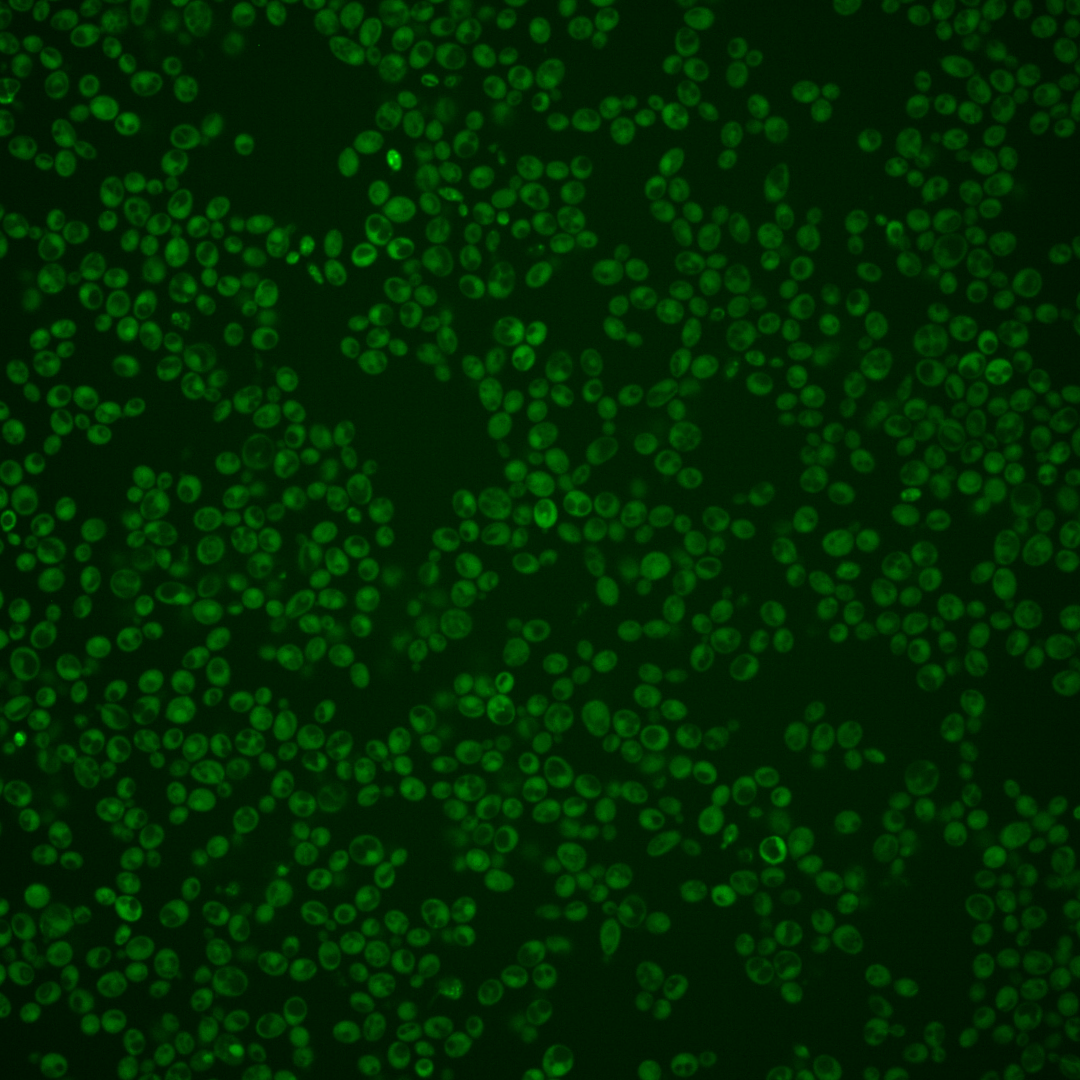
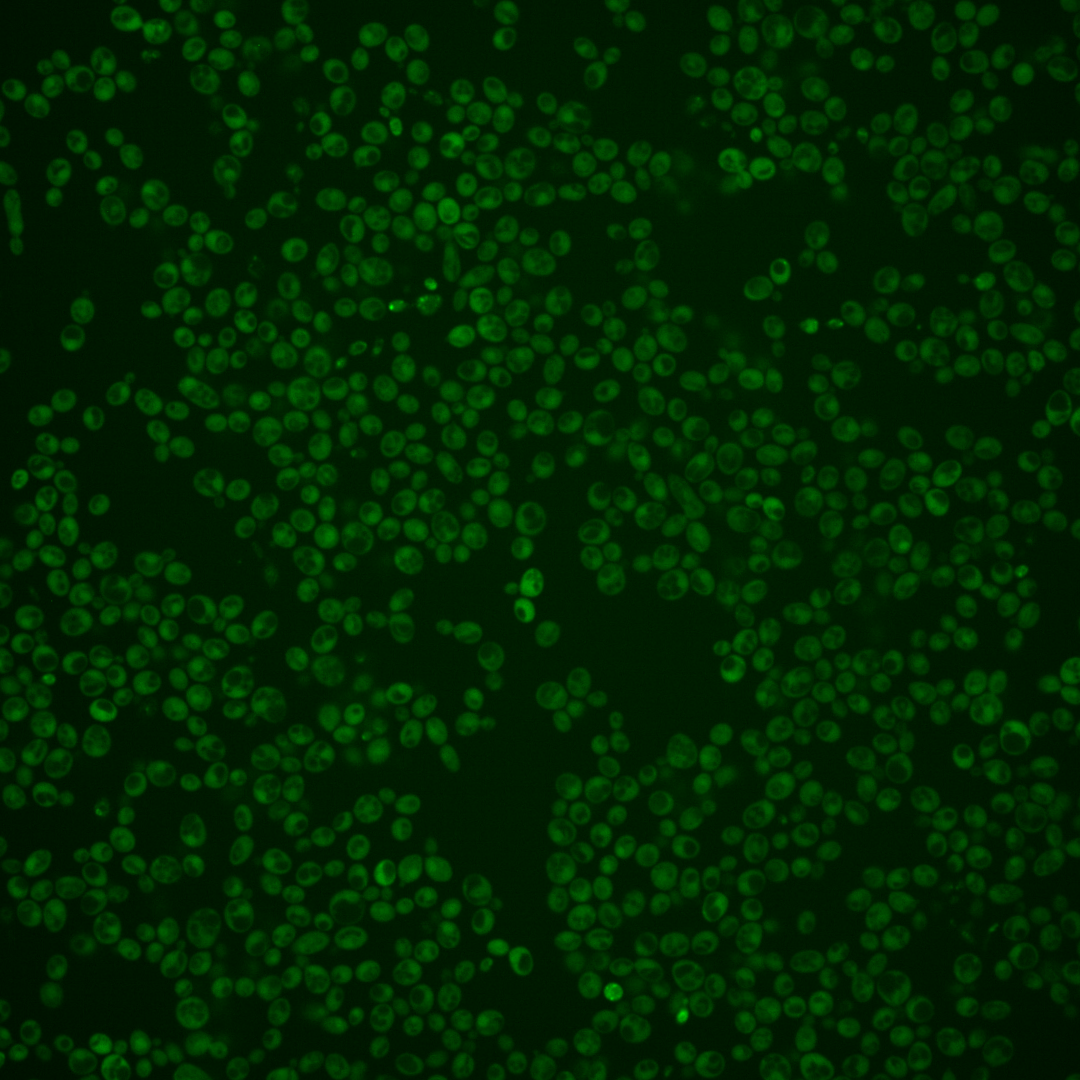
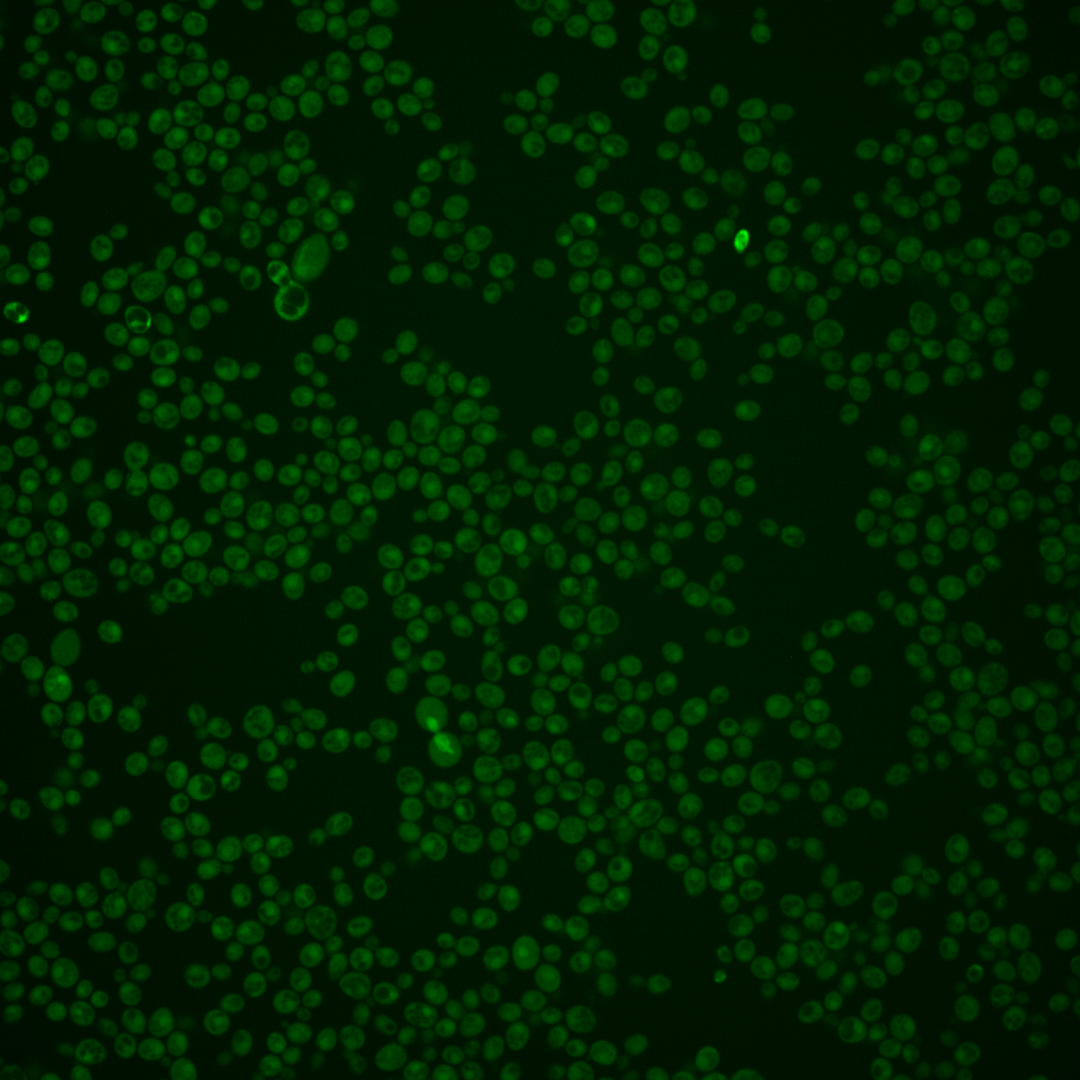
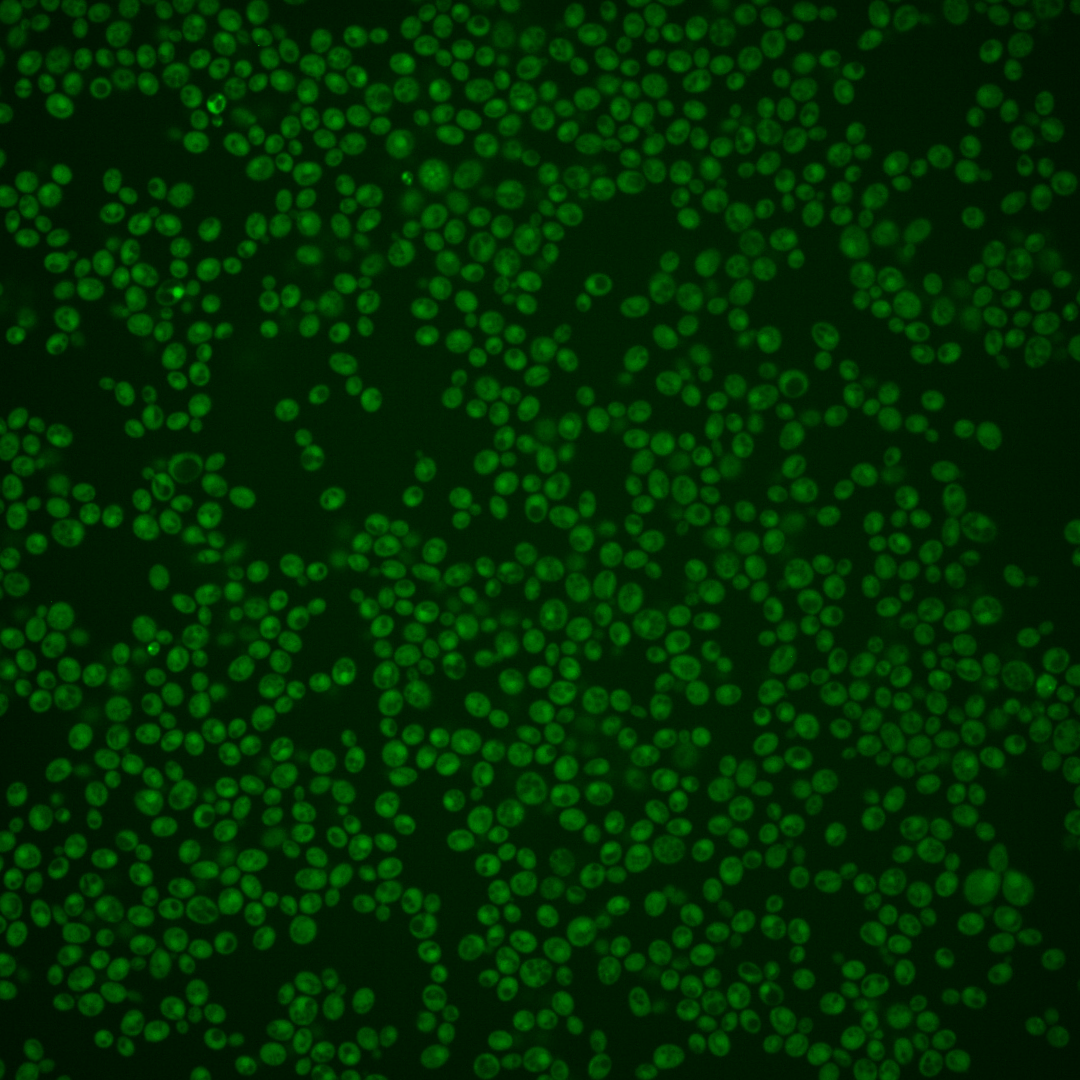

| Standard name | |
|---|---|
| Human Ortholog | |
| Description | Dual-specificity protein phosphatase; maintains low levels of both basal and induced cell integrity pathway signaling by dephosphorylation of the Slt2p MAPK; reciprocally regulated by Slt2p through phosphorylation; minor role with Ptp2p in the adaptive response to pheromone through the dephosphorylation of the Fus3p MAPK with major contribution by Ptp3p; inhibits the nuclear accumulation of Fus3p; two isoforms exist as the result of alternative translation initiation starts |
Micrographs




















































































Sub-cellular Localization
Yeast GFP Assignment
Protein Abundance
Localization Change
External localization resources
| ensLOC | DeepLoc | |||||||||||||||||||||||
|---|---|---|---|---|---|---|---|---|---|---|---|---|---|---|---|---|---|---|---|---|---|---|---|---|
| Localization | WT1 | WT2 | WT3 | RAP60 | RAP140 | RAP220 | RAP300 | RAP380 | RAP460 | RAP540 | RAP620 | RAP700 | HU80 | HU120 | HU160 | rpd3Δ_1 | rpd3Δ_2 | rpd3Δ_3 | WT1 | WT2 | WT3 | AF100 | AF140 | AF180 |
| Cortical Patches | 0 | 0 | 0 | 0 | 0 | 0 | 0 | 0 | 0 | 0 | 0 | 0 | 0 | 0 | 0 | 0 | 0 | 0 | 1 | 0 | 1 | 0 | 1 | 0 |
| Bud | 1 | 0 | 0 | 2 | 2 | 0 | 0 | 3 | 0 | 3 | 1 | 0 | 2 | 0 | 1 | 1 | 0 | 0 | 4 | 0 | 0 | 1 | 1 | 0 |
| Bud Neck | 0 | 0 | 0 | 0 | 0 | 0 | 0 | 0 | 0 | 0 | 0 | 0 | 0 | 0 | 0 | 0 | 0 | 0 | 1 | 0 | 0 | 0 | 0 | 0 |
| Bud Site | 0 | 0 | 0 | 0 | 0 | 0 | 0 | 0 | 0 | 0 | 0 | 0 | 0 | 0 | 0 | 0 | 0 | 0 | – | – | – | – | – | – |
| Cell Periphery | 1 | 1 | 1 | 2 | 1 | 1 | 2 | 0 | 1 | 3 | 1 | 2 | 1 | 0 | 0 | 3 | 2 | 4 | 0 | 0 | 0 | 0 | 0 | 0 |
| Cytoplasm | 274 | 122 | 109 | 100 | 87 | 155 | 197 | 178 | 101 | 171 | 83 | 100 | 225 | 223 | 269 | 129 | 113 | 46 | 277 | 115 | 109 | 115 | 169 | 127 |
| Endoplasmic Reticulum | 0 | 1 | 1 | 1 | 0 | 0 | 0 | 0 | 0 | 0 | 3 | 1 | 2 | 0 | 0 | 10 | 7 | 2 | 0 | 0 | 1 | 0 | 3 | 5 |
| Endosome | 0 | 0 | 0 | 1 | 1 | 0 | 1 | 0 | 0 | 0 | 1 | 0 | 0 | 0 | 1 | 1 | 3 | 0 | 3 | 0 | 2 | 1 | 2 | 0 |
| Golgi | 0 | 0 | 0 | 1 | 0 | 0 | 0 | 0 | 0 | 0 | 0 | 0 | 0 | 1 | 0 | 1 | 1 | 0 | 2 | 0 | 0 | 0 | 1 | 1 |
| Mitochondria | 16 | 1 | 3 | 13 | 4 | 38 | 59 | 66 | 73 | 113 | 83 | 81 | 0 | 3 | 0 | 5 | 0 | 1 | 2 | 0 | 1 | 0 | 1 | 0 |
| Nucleus | 2 | 0 | 0 | 3 | 0 | 3 | 1 | 1 | 0 | 0 | 1 | 1 | 0 | 0 | 0 | 0 | 0 | 3 | 0 | 0 | 0 | 0 | 0 | 0 |
| Nuclear Periphery | 2 | 1 | 2 | 1 | 0 | 0 | 1 | 0 | 0 | 0 | 0 | 0 | 0 | 0 | 1 | 0 | 0 | 0 | 0 | 1 | 1 | 0 | 0 | 0 |
| Nucleolus | 1 | 0 | 1 | 0 | 0 | 0 | 1 | 0 | 0 | 1 | 0 | 0 | 0 | 0 | 0 | 2 | 0 | 0 | 0 | 0 | 0 | 0 | 0 | 0 |
| Peroxisomes | 0 | 0 | 0 | 0 | 0 | 0 | 0 | 0 | 0 | 0 | 0 | 0 | 0 | 0 | 0 | 0 | 0 | 0 | 0 | 0 | 0 | 0 | 0 | 0 |
| SpindlePole | 0 | 0 | 0 | 0 | 0 | 0 | 0 | 0 | 0 | 0 | 0 | 1 | 1 | 0 | 0 | 0 | 0 | 0 | 1 | 0 | 0 | 0 | 0 | 0 |
| Vac/Vac Membrane | 3 | 1 | 1 | 1 | 0 | 0 | 7 | 3 | 1 | 6 | 1 | 3 | 0 | 0 | 0 | 2 | 6 | 2 | 1 | 6 | 3 | 0 | 0 | 0 |
| Unique Cell Count | 287 | 124 | 115 | 108 | 89 | 164 | 228 | 208 | 147 | 223 | 145 | 151 | 228 | 224 | 271 | 135 | 120 | 52 | 299 | 127 | 131 | 121 | 188 | 138 |
| Labelled Cell Count | 300 | 127 | 118 | 125 | 95 | 197 | 269 | 251 | 176 | 297 | 174 | 189 | 231 | 227 | 272 | 154 | 132 | 58 | 299 | 127 | 131 | 121 | 188 | 138 |
Yeast GFP Assignment
Protein Abundance
| Screen | WT1 | WT2 | WT3 | RAP60 | RAP140 | RAP220 | RAP300 | RAP380 | RAP460 | RAP540 | RAP620 | RAP700 | HU80 | HU120 | HU160 | rpd3Δ_1 | rpd3Δ_2 | rpd3Δ_3 | AF100 | AF140 | AF180 |
|---|---|---|---|---|---|---|---|---|---|---|---|---|---|---|---|---|---|---|---|---|---|
| Mean Cell GFP Intensity (1e-4) | 4.8 | 5.8 | 5.4 | 4.9 | 5.3 | 4.6 | 4.2 | 4.1 | 4.5 | 3.9 | 4.1 | 3.8 | 5.8 | 5.4 | 5.6 | 7.1 | 9.1 | 8.8 | 6.8 | 7.4 | 8.7 |
| Std Deviation (1e-4) | 0.6 | 1.2 | 1.4 | 1.3 | 1.7 | 1.4 | 1.6 | 1.0 | 1.9 | 1.5 | 1.4 | 1.5 | 0.9 | 1.1 | 1.1 | 1.9 | 3.3 | 2.5 | 1.5 | 1.6 | 1.8 |
| Intensity Change (Log2) | – | – | – | -0.13 | -0.03 | -0.23 | -0.37 | -0.39 | -0.27 | -0.48 | -0.41 | -0.51 | 0.09 | 0.01 | 0.05 | 0.4 | 0.75 | 0.71 | 0.33 | 0.44 | 0.68 |
Localization Change
| Localization | RAP60 | RAP140 | RAP220 | RAP300 | RAP380 | RAP460 | RAP540 | RAP620 | RAP700 | HU80 | HU120 | HU160 | rpd3Δ_1 | rpd3Δ_2 | rpd3Δ_3 |
|---|---|---|---|---|---|---|---|---|---|---|---|---|---|---|---|
| Cortical Patches | 0 | 0 | 0 | 0 | 0 | 0 | 0 | 0 | 0 | 0 | 0 | 0 | 0 | 0 | 0 |
| Bud | 0 | 0 | 0 | 0 | 0 | 0 | 0 | 0 | 0 | 0 | 0 | 0 | 0 | 0 | 0 |
| Bud Neck | 0 | 0 | 0 | 0 | 0 | 0 | 0 | 0 | 0 | 0 | 0 | 0 | 0 | 0 | 0 |
| Bud Site | 0 | 0 | 0 | 0 | 0 | 0 | 0 | 0 | 0 | 0 | 0 | 0 | 0 | 0 | 0 |
| Cell Periphery | 0 | 0 | 0 | 0 | 0 | 0 | 0 | 0 | 0 | 0 | 0 | 0 | 0 | 0 | 0 |
| Cytoplasm | -0.7 | 1.1 | -0.1 | -2.4 | -2.5 | -5.3 | -4.2 | -6.8 | -5.6 | 2.1 | 2.9 | 2.8 | 0.3 | -0.2 | -1.5 |
| Endoplasmic Reticulum | 0 | 0 | 0 | 0 | 0 | 0 | 0 | 0 | 0 | 0 | 0 | 0 | 2.5 | 0 | 0 |
| Endosome | 0 | 0 | 0 | 0 | 0 | 0 | 0 | 0 | 0 | 0 | 0 | 0 | 0 | 0 | 0 |
| Golgi | 0 | 0 | 0 | 0 | 0 | 0 | 0 | 0 | 0 | 0 | 0 | 0 | 0 | 0 | 0 |
| Mitochondria | 2.7 | 0 | 0 | 0 | 0 | 0 | 0 | 0 | 0 | 0 | 0 | 0 | 0 | 0 | 0 |
| Nucleus | 0 | 0 | 0 | 0 | 0 | 0 | 0 | 0 | 0 | 0 | 0 | 0 | 0 | 0 | 0 |
| Nuclear Periphery | 0 | 0 | 0 | 0 | 0 | 0 | 0 | 0 | 0 | 0 | 0 | 0 | 0 | 0 | 0 |
| Nucleolus | 0 | 0 | 0 | 0 | 0 | 0 | 0 | 0 | 0 | 0 | 0 | 0 | 0 | 0 | 0 |
| Peroxisomes | 0 | 0 | 0 | 0 | 0 | 0 | 0 | 0 | 0 | 0 | 0 | 0 | 0 | 0 | 0 |
| SpindlePole | 0 | 0 | 0 | 0 | 0 | 0 | 0 | 0 | 0 | 0 | 0 | 0 | 0 | 0 | 0 |
| Vacuole | 0 | 0 | 0 | 0 | 0 | 0 | 0 | 0 | 0 | 0 | 0 | 0 | 0 | 0 | 0 |
External localization resources
Images






























Protein Concentration and Protein Localization Data
| R1 | R2 | R3 | ||||||||||||||||
|---|---|---|---|---|---|---|---|---|---|---|---|---|---|---|---|---|---|---|
| G1 Pre-START | G1 Post-START | S/G2 | Metaphase | Anaphase | Telophase | G1 Pre-START | G1 Post-START | S/G2 | Metaphase | Anaphase | Telophase | G1 Pre-START | G1 Post-START | S/G2 | Metaphase | Anaphase | Telophase | |
| Concentration | 1.0007 | 1.5515 | 1.1727 | 1.0887 | 1.0047 | 1.4475 | 2.1143 | 2.738 | 2.3619 | 2.1799 | 2.1918 | 2.0448 | 3.2482 | 3.0783 | 2.8384 | 2.9202 | 2.4655 | 2.9749 |
| Actin | 0.0171 | 0.0003 | 0.0074 | 0.0009 | 0.0402 | 0.0047 | 0.0457 | 0.0234 | 0.0227 | 0.0669 | 0.035 | 0.0007 | 0.1114 | 0.0002 | 0.0442 | 0.0006 | 0.0002 | 0.0176 |
| Bud | 0.0002 | 0.003 | 0.0021 | 0.0001 | 0.0001 | 0.0007 | 0.001 | 0.0021 | 0.0034 | 0.0003 | 0.003 | 0.0004 | 0.0011 | 0 | 0.0008 | 0.0001 | 0 | 0.0001 |
| Bud Neck | 0.0031 | 0.0002 | 0.0008 | 0.0002 | 0.0012 | 0.0027 | 0.0259 | 0.0002 | 0.0023 | 0.0002 | 0.0016 | 0.0009 | 0.0064 | 0.0001 | 0.0012 | 0.0001 | 0.0001 | 0.0004 |
| Bud Periphery | 0.0004 | 0.0009 | 0.0034 | 0.0001 | 0.0001 | 0.0009 | 0.0019 | 0.0015 | 0.0064 | 0.0003 | 0.0049 | 0.0005 | 0.0018 | 0 | 0.0011 | 0 | 0 | 0.0001 |
| Bud Site | 0.0011 | 0.0033 | 0.0082 | 0.0002 | 0.0003 | 0.0018 | 0.0099 | 0.0132 | 0.0112 | 0.0009 | 0.0117 | 0.0001 | 0.0053 | 0.0003 | 0.0024 | 0.0001 | 0 | 0.0001 |
| Cell Periphery | 0.0002 | 0.0003 | 0.0003 | 0.0001 | 0.0001 | 0.0002 | 0.0014 | 0.0002 | 0.0005 | 0.0001 | 0.0002 | 0.0001 | 0.0005 | 0.0002 | 0.0003 | 0 | 0 | 0.0001 |
| Cytoplasm | 0.5129 | 0.6422 | 0.6047 | 0.6515 | 0.6055 | 0.6778 | 0.3255 | 0.4779 | 0.4926 | 0.5156 | 0.599 | 0.6729 | 0.4054 | 0.7433 | 0.5323 | 0.6878 | 0.675 | 0.5949 |
| Cytoplasmic Foci | 0.0227 | 0.0072 | 0.0126 | 0.0109 | 0.0061 | 0.0124 | 0.0441 | 0.0083 | 0.0189 | 0.0052 | 0.0523 | 0.0084 | 0.0286 | 0.0031 | 0.0139 | 0.0131 | 0.0018 | 0.0071 |
| Eisosomes | 0.0003 | 0.0001 | 0.0001 | 0.0001 | 0.0007 | 0.0001 | 0.0005 | 0.0001 | 0.0002 | 0.0001 | 0.0003 | 0 | 0.0008 | 0 | 0.0009 | 0 | 0 | 0.0001 |
| Endoplasmic Reticulum | 0.0041 | 0.0043 | 0.0033 | 0.0057 | 0.0027 | 0.0016 | 0.0081 | 0.0021 | 0.0033 | 0.0016 | 0.0016 | 0.0027 | 0.0061 | 0.0018 | 0.0029 | 0.0019 | 0.0008 | 0.0023 |
| Endosome | 0.0087 | 0.0039 | 0.0053 | 0.0067 | 0.0017 | 0.0043 | 0.0471 | 0.0026 | 0.0131 | 0.0016 | 0.0173 | 0.0039 | 0.0196 | 0.0004 | 0.0071 | 0.0144 | 0.0003 | 0.0018 |
| Golgi | 0.0041 | 0.0003 | 0.0017 | 0.0004 | 0.0016 | 0.0016 | 0.0245 | 0.003 | 0.0065 | 0.002 | 0.0162 | 0.0001 | 0.0124 | 0.0001 | 0.0047 | 0.0006 | 0 | 0.0008 |
| Lipid Particles | 0.0038 | 0.0005 | 0.0062 | 0.0005 | 0.0026 | 0.0039 | 0.0186 | 0.0016 | 0.0072 | 0.0003 | 0.02 | 0.0001 | 0.0133 | 0.0001 | 0.0081 | 0.0004 | 0 | 0.0002 |
| Mitochondria | 0.0056 | 0.0002 | 0.0079 | 0.0002 | 0.0012 | 0.001 | 0.0084 | 0.0027 | 0.0024 | 0.0005 | 0.0081 | 0.0001 | 0.0046 | 0.0001 | 0.0088 | 0.0002 | 0.0001 | 0.0002 |
| None | 0.3925 | 0.3268 | 0.3182 | 0.317 | 0.318 | 0.2719 | 0.3993 | 0.4489 | 0.385 | 0.4018 | 0.1966 | 0.3061 | 0.3447 | 0.2481 | 0.3365 | 0.2419 | 0.3206 | 0.3712 |
| Nuclear Periphery | 0.0016 | 0.0008 | 0.001 | 0.0013 | 0.0011 | 0.0017 | 0.004 | 0.0003 | 0.0024 | 0.0004 | 0.0008 | 0.0003 | 0.0036 | 0.0003 | 0.0073 | 0.0006 | 0.0001 | 0.0007 |
| Nucleolus | 0.0003 | 0.0002 | 0.0003 | 0.0001 | 0.0001 | 0.0018 | 0.0022 | 0.0001 | 0.0018 | 0 | 0.0003 | 0.0001 | 0.0008 | 0 | 0.0027 | 0 | 0 | 0 |
| Nucleus | 0.0029 | 0.0021 | 0.0019 | 0.0017 | 0.0024 | 0.0031 | 0.0028 | 0.0007 | 0.0049 | 0.0005 | 0.001 | 0.0009 | 0.0023 | 0.0011 | 0.0069 | 0.0011 | 0.0005 | 0.0005 |
| Peroxisomes | 0.0147 | 0.0001 | 0.0114 | 0.0002 | 0.0119 | 0.003 | 0.0197 | 0.01 | 0.0049 | 0.0007 | 0.0257 | 0.0001 | 0.0115 | 0 | 0.0089 | 0.0339 | 0 | 0.0009 |
| Punctate Nuclear | 0.0017 | 0.0006 | 0.0012 | 0.0009 | 0.002 | 0.0036 | 0.0034 | 0.0004 | 0.0039 | 0.0002 | 0.003 | 0.0009 | 0.0174 | 0.0003 | 0.0069 | 0.0005 | 0.0001 | 0.0005 |
| Vacuole | 0.0015 | 0.0025 | 0.0017 | 0.0009 | 0.0004 | 0.0011 | 0.0048 | 0.0005 | 0.0056 | 0.0007 | 0.0011 | 0.0005 | 0.0016 | 0.0005 | 0.0014 | 0.0019 | 0.0001 | 0.0003 |
| Vacuole Periphery | 0.0006 | 0.0002 | 0.0003 | 0.0002 | 0.0001 | 0.0002 | 0.0013 | 0.0001 | 0.0008 | 0.0001 | 0.0003 | 0.0001 | 0.0007 | 0 | 0.0008 | 0.0006 | 0 | 0.0001 |
Sequencing Data
| R1 | R2 | |||||||||
|---|---|---|---|---|---|---|---|---|---|---|
| G1 Post-START | S/G2 | Metaphase | Anaphase | Telophase | G1 Post-START | S/G2 | Metaphase | Anaphase | Telophase | |
| Gene Expression | 9.758 | 17.4461 | 12.4479 | 13.3524 | 19.4641 | 9.0024 | 15.9436 | 11.9056 | 13.3854 | 12.7701 |
| Translational Efficiency | 0.6636 | 0.7475 | 0.814 | 0.6741 | 0.4981 | 0.7981 | 0.7986 | 1.0311 | 0.67 | 0.8071 |
Hit Data
| Dataset | Hit |
|---|---|
| Protein Concentration | ✘ |
| Protein Localization | ✘ |
| Gene Expression | ✘ |
| Translational Efficiency | ✘ |
Endocytosis
| Temp | Actin Patch (Sac6-tdTomato) | Cortical Patch (Sla1-GFP) | Late Endosome (Snf7-GFP) | Vacuole (Vph1-GFP) |
|---|---|---|---|---|
| 37℃ | ||||
| RT |
Cell Cycle Omics
CYCLoPs (Msg5-GFP)
| Gene / Allele | Actin Patch (Sac6-tdTomato) | Cortical Patch (Sla1-GFP) | Late Endosome (Snf7-GFP) | Vacuole (Sac6-tdTomato) |
|---|
| Gene | Images |
|---|
| Gene | Images |
|---|
Images are not yet available
Images are not yet available